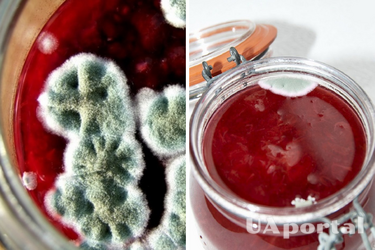
Заморозьте и прокипятите: что делать с вареньем, на котором появилась плесень

Заморозьте и прокипятите: что делать с вареньем, на котором появилась плесень
Иногда открывая банку с вареньем вы с сожалением замечали, что на нем появилась плесень. Многие не обращают на это внимания, убирают плесень, кипятят варенье и употребляют в пищу. UaPortal разбирался, можно ли есть такое варенье и что с ним делать.
Почему на варенье появляется плесень:
– при приготовлении использовались влажные ягоды;
–в варенье мало сахара;
–банка с вареньем хранилась в сыром помещении;
– недостаточно долго кипятили варенье и оно не пропиталось сахаром;
–в банку попало много воздуха.
Читайте также: Максимум пользы в одной баночке: как сварить варенье из цветов одуванчика
Чтобы избежать появления плесени, варите варенье только в солнечный, сухой день. В банки разливайте горячее варенье.
Можно ли есть варенье, на котором образовалась плесень
Врачи отвечают однозначно – нет. Плесень может вызвать аллергию, дисбактериоз и другие неприятности. Если вам очень жаль выбрасывать варенье, снимите плесень ложкой, стараясь не касаться нижних слоев. Попробуйте его – если нет привкуса и запаха плесени, переложите варенье в чистую банку и поставьте ее в морозилку, чтобы уничтожить споры. Также варенье можно прокипятить – налейте варенье, предварительно сняв плесень, в кастрюлю и добавьте сахар (200 г сахара/1 литр), варите, пока не появится пена. Ее снимите и выбросьте, а варенье быстро съешьте. Можно использовать такое варенье как начинку для выпечки.
Обратите внимание: варенье можно спасти, если слой плесени не больше 2 см. Если после уборки плесени вы все равно чувствуете ее запах или вкус – выбрасывайте продукт.
Советуем вам обратить внимание на три рецепта сочного варенья из яблок, апельсинов и винограда.
Хотите получать самые актуальные новости о войне и событиях в Украине – подписывайтесь на наш Телеграмм-канал!